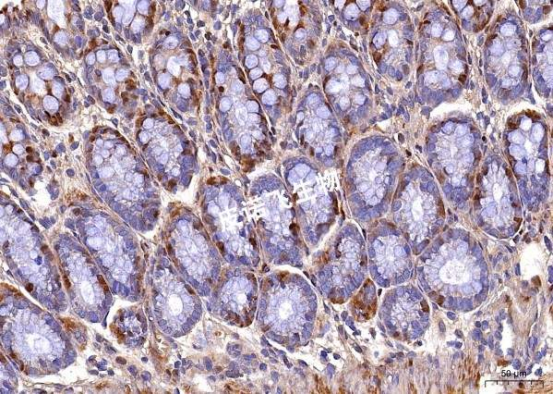
image.png

服务介绍:
原位杂交原理:原位杂交是指将特定标记的已知序列核酸为探针与细胞或组织切片中核酸进行杂交,从而对特定核酸顺序进行精确定量定位的过程。原位杂交可以在细胞标本或组织标本上进行。
实验结果展示:
1、mRNA DAB显色 胃

2、circ-RNA 探针 DAB显色 肠
实验流程:
1、组织固定:组织取出洗净后立即放入固定液(DEPC水配制)中固定2-12h。
2、脱水:组织固定完成后经梯度酒精脱水后浸蜡,包埋。
3、切片:石蜡经切片机切片,摊片机捞片,62°烤箱烤片2h。
4、石蜡切片脱蜡至水:依次将切片放入二甲苯Ⅰ15min-二甲苯Ⅱ15min-无水乙醇Ⅰ5min-无水乙醇Ⅱ5min-85%酒精5min-75%酒精5min-DEPC水洗。
5、消化:根据组织固定时间长短,切片于修复液中煮沸10-15分钟,自然冷却。后基因笔画圈,根据不同组织不同指标特性,滴加蛋白酶K(20ug/ml) 37°消化20-30 min。纯水冲洗后PBS洗3次×5min。
6、阻断内源性过氧化物酶:滴加3%甲醇-H2O2,室温避光孵育15min,将玻片置于PBS(PH7.4)中在脱色摇床上晃动洗涤3次,每次5min。
7、预杂交:滴加预杂交液,37°C孵育1h。
8、杂交:倾去预杂交液,滴加含探针杂交液, 恒温箱 37度杂交过夜。
9、杂交后洗涤:洗去杂交液,2×SSC,37°C 洗10min,1×SSC,37°C洗2×5min,0.5×SSC室温洗10min。若非特异杂交体较多,可以增加甲酰胺洗涤。
10、滴加封闭液:滴加封闭血清正常兔血清。室温30min。
11、滴加鼠抗地高辛标记过氧化物酶(anti-DIG-HRP):倾去封闭液,滴加anti-DIG-HRP。37°C孵育40min,后PBS洗4次×5min。
12、DAB显色:切片稍甩干后,在圈内滴加新鲜配制的DAB显色液,显微镜下控制显色时间,阳性为棕黄色,纯水冲洗切片终止显色。
13、复染细胞核:Harris苏木素复染3min左右,自来水洗,1%盐酸酒精分化数秒,自来水洗,氨水返蓝,流水冲洗。
14、脱水封片:将切片依次放入75%酒精6min-85%酒精6min—100%酒精I 6min—100%酒精II 6min-正丁醇6min—二甲苯透明,将切片从二甲苯中拿出稍晾干后,中性树胶封片。
15、显微镜检,图像采集分析。
结果判读:
阳性为棕黄色,细胞核为蓝色。
送样要求:
1、切片前处理要求:新鲜组织干冰运输后做冰冻切片;或取
2mm左右厚度的新鲜组织,5min内投入原位杂交固定液内固定,4℃低温保存运输,切勿冷冻结冰,尽快包埋切片后进行原位杂交实验,固定时间过长影响核酸检出率;
2、冰冻切片:冰冻切片-20℃运输;
3、石蜡切片:石蜡切片常温运输;
4、细胞爬片:细胞爬片加原位杂交固定液固定15min后,换无酶PBS,密封,4℃运输。
单据填写:
1、探针合成:需提供待测目的基因序列或基因登录号、所需标记类型;
2、自带探针需告知完整探针信息;
3、写明检测要求。
仅供科研用途,不可用于临床诊断!